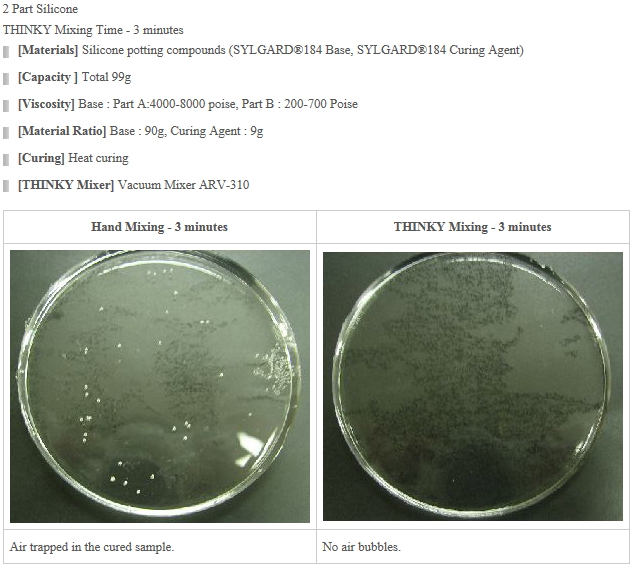

ARV-5000(Maximum capacity : 5 kg) | Vacuum Type

Benefits
● 3L・5kg의 대용량
● 최적의 재료 레시피 설정이 가능하여 작업 중 재료가 넘칠 일이 없습니다.
● 회전수를 변경하여 재료에 따른 최적의 설정이 가능합니다.
● 터치패널로 조작성이 뛰어납니다.
● 회전에 의한 냉각 기능 탑재
● 다양한 용기 지원
● CE 인증 모델 사용 가능
Feature
● 3L/5kg의 혼합, 분산, 탈기 성능을 갖추고 있어 대량 생산에 적용할 수 있습니다.
● 대형 챔버는 제조 수준에서 효율성을 높이기 위해 많은 양을 혼합하고 탈기할 수 있습니다.
● 진공 기술을 결합하면 고점도 재료를 서브미크론 수준에서 완전히 탈기할 수 있습니다.
유성원심믹서의 원리 및 특성
고점도 물질을 교반 날개 없이 교반할 수 있는 이유
유성원심믹서는 교반날개를 사용하지 않고 재료를 교반하면서 동시에 탈기할 수 있는 장치이다.
이를 실현하기 위해서는 세 가지 중요한 요소가 있습니다.
(1) 회전 : 원심력으로 재료를 중심에서 멀어지게 이동시킵니다.
(2) 회전: 용기를 회전시키면 재료의 흐름(회전 및 전단)이 발생합니다.
(3) 45도: 회전축을 45도 기울여 입체적인 흐름을 만들어냅니다.



또한 액체 표면과 용기 벽 사이에서 유속(방향)이 급격하게 변화하여 복잡한 흐름과 강한 전단력이 발생합니다. 이 전단력은 물방울과 입자를 더 작게 만들고 분산성을 증가시킵니다. 동시에 기포도 미세하게 분산됩니다.
그 결과, 교반날개를 사용하지 않고도 고점도의 물질이라도 단시간에 균일하게 교반하는 것이 가능하다.
대기압형과 진공형의 차이
Thinky Mixer의 유성 원심 믹서는 대기압 유형과 진공 유형의 두 가지 유형으로 구성됩니다.
교반 과정에서 기포가 발생하는 경우가 종종 있는데, 이 경우 목적과 용도에 따라 두 가지 형태 중 하나를 사용하면 됩니다.
대기압식 믹서는 육안으로 보이는 수백 미크론 수준의 기포를 제거할 수 있습니다.
눈에 보이지 않는 미크론 크기의 기포를 제거하려는 경우 진공형 믹서를 사용할 수 있습니다.
종래에는 믹서로 교반한 후 데시케이터 등으로 탈기를 진행하는데 시간이 오래 걸렸다.
유성형 원심믹서는 넘칠 염려 없이 교반하면서 탈기를 달성할 수 있어 시간을 대폭 단축할 수 있습니다.
대기압식 탈기(비교적 점도가 낮은 재료에 적합)
대부분의 대기압식 믹서에는 “탈기 모드”가 장착되어 있습니다.
회전 속도와 회전 속도의 균형을 변경함으로써 다음 원리에 따라 탈기가 발생합니다.
(1) “회전에 의한 원심력”에 의해 액체 표면에 가벼운 기포가 발생합니다.
(2) 기포를 삼키지 않는 느린 회전(즉, 탈기 모드)을 적용함으로써 액체 표면에 올라온 기포가 전단력에 의해 파괴됩니다.

진공형 소포(비교적 점도가 높은 재료에 적합)
소포는 다음 원리에 기초하여 이루어집니다.
1. 점도가 높으면 기포 상승 속도가 느리고 재료의 대류에 의해 기포가 표면으로 운반됩니다.
2. 기포는 압력이 감소하여 팽창하여 파괴됩니다. 용매 가스 거품도 나타납니다.
3. “회전”에 의한 전단력에 의해 액체 표면의 작은 기포도 파괴됩니다.

Planetary Centrifugal Mixer의 주요 특징
높은 점성의 물질이라도 작은 양으로 짧은 시간에 믹싱 처리 가능
Filler 같은 물질도 Shearing 없이 Dispersing 가능
작업자가 달라도 Dispersion 결과에
있어서 높은 재현성
짧은 시간 작업에도
탁월한 AIR BUBBLE 제거
높은점성의 물질(실런트,도료,안료등)
에서도 Deaeration가능
처리샘플의
Loss 방지 극대화
손쉬운 운전과
메모리기능
Impeller-less운전으로
클리닝 필요가 없음
적은 용량에서 큰용량까지
Scale up 가능
Carbon Nano Fiber

Carbon Nano Tube(1.0, vol %)

Alumina Oxide

2 Part epoxy in Extream Viscosity Difference

Carbon Black + Two-part Silicon

2 Part Silicon
Specifications
| Model | ARV-5000 | |
|---|---|---|
| Maximum Capacity[1] | 5 kg | |
| Standard Container[2] | 4 liter resin container | |
| Power Supply |
Voltage: Three-phaseAC 200 V ± 10 %, 50/60 Hz Power consumption:Approx. 35 VA (standby) Max 4500 VA (operation) |
|
| Unit Dimensions | H 1650 x W 1050 x D 950(mm) | |
| Unit weight | Approx. 530 kg | |
| Accessories |
Instruction Manual x 1, Power cable x 1, Containers and others: Depending
on specifications, Vacuum tube x 1, Others (depending on specifications) |
|
| Option | External host communication function | |
|
[1]:Total mass to mount on the cup holder, including materials,
containers, and adapters. [2]:Contact us because the actual volume of mixing may vary depending on the containers, materials, and conditions. |
||

